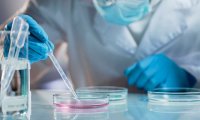
В США обнаружили случай заболевания китайским коронавирусом

Китай уступил лидерство Японии на рынке частных самолетов в новом году
Китайский рынок частных самолетов значительно пострадать в 2019 году от экономического спада, торговой войны с США, а также нехватки инфраструктуры и квалифицированных кадров в этой сфере.